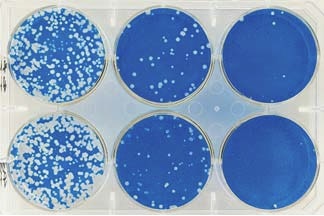

プラークアッセイ できない細胞
2

Ensightを用いたプラークアッセイ Perkinelmer Japan
抗ウイルス性 繊維製品 一般財団法人カケンテストセンター


エムエステクノシステムズ コロニー プラークカウント等のバイオアッセイ解析

ウイルスによる細胞変性効果をラベルフリーでハイスループットに測定 株式会社スクラム

2015 043777号 e3 19kタンパク質の小胞体保持ドメインに突然変異を有するアデノウイルス及び癌治療におけるその用途 Astamuse

ウイルスによる細胞変性効果をラベルフリーでハイスループットに測定 株式会社スクラム

エムエステクノシステムズ コロニー プラークカウント等のバイオアッセイ解析
Article
2

次亜塩素酸水 スプレー オックス Oxミスト 300ml 除 おとぎの国 マリアージュ ポンパレモール
You have just read the article entitled プラークアッセイ できない細胞. You can also bookmark this page with the URL : https://anxipoxxy.blogspot.com/2022/09/blog-post_892.html
0 Response to "プラークアッセイ できない細胞"
Post a Comment